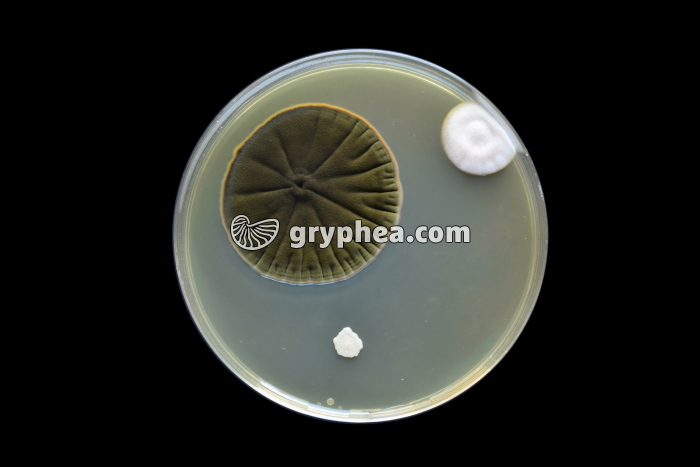
Moisissures - Développement de colonies sur gélose (contaminations accidentelles) - gryphea.com

1 crédit = 6.00€ TTC
(Hors pack)
si vous êtes enseignant, le site gryphea.org a été conçu spécialement pour vous !
La technique de culture des bactéries consiste à étaler au mieux une goutte de liquide contenant les bactéries à étudier sur toute la surface d'une gélose nutritive d'une boite de Pétri, de façon à répartir les germes de manière homogène.
Les boites ainsi ensemencées sont alors mises à l'étuve (température voisine de 37 °C) pendant 24 à 72h. Dans ces conditions de température, chaque bactérie présente sur le milieu nutritif se multiplie rapidement, engendrant en quelques dizaines d’heures un amas de plusieurs millions de cellules issu de ses divisions successives. Chaque clone de bactéries ainsi formé finit par devenir visible à l’oeil nu à la surface de la gélose, sous la forme d’une petite tache claire, plus ou moins en relief. Quand le nombre de bactéries ensemencées est important, un tapis assez uniforme de colonies bactériennes se développe[...]
La suite du commentaire est réservée aux inscrits, créez un compte gratuitement.